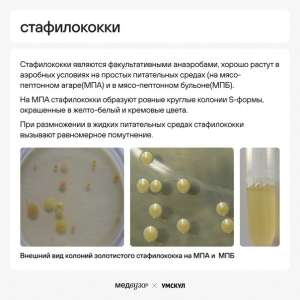
Image

2 годы назад
2 годы назад
Если я сама тебе напишу ты обещаешь со мной пойти на встречу, пройти прогуляться или просто выпить кофе а там уже как получиться?
2 годы назад
2 годы назад
2 годы назад
2 годы назад
Стафилококки, стрептококки…так похожи, но всё же очень разные!
- микробиологическая характеристика
- заболевания, которые вызывают
- основные отличия и сходства
Всё это в нашем посте, сохраняй и не путай💙
- микробиологическая характеристика
- заболевания, которые вызывают
- основные отличия и сходства
Всё это в нашем посте, сохраняй и не путай💙
Показать больше
2 годы назад
Ингибиторы протонной помпы 💊
- механизм действия
- представители группы
- показания к применению
- нежелательные реакции
- сравнительная характеристика препаратов
Сохраняй! 💙
- механизм действия
- представители группы
- показания к применению
- нежелательные реакции
- сравнительная характеристика препаратов
Сохраняй! 💙
При финансовой поддержке
Memes Admin
5 мс. назад